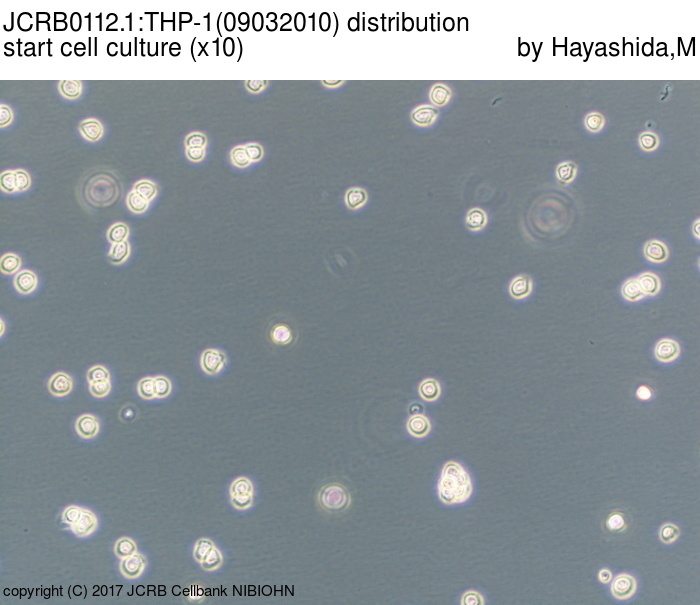
JCRB01121_THP1_09032010_003.JPG

たにひろ様 THP 1ml Detailed Information [JCRB0112.1]-
(4008件)
Pontaパス特典
サンキュー配送
10150円(税込)
102ポイント(1%)
Pontaパス会員ならさらに+1%ポイント還元!
送料
(
)
4004
配送情報
お届け予定日:2026.06.07 12:0までにお届け
※一部地域・離島につきましては、表示のお届け予定日期間内にお届けできない場合があります。
ロットナンバー
85603115508
お買い物の前にチェック!

Pontaパス会員なら
ポイント+1%
ポイント+1%
商品説明

1500円割引
| カテゴリー: | ダイエット・健康>>>リラクゼーション>>>リラクゼーショングッズ |
|---|---|
| 商品の状態: | 新品、未使用","新品で購入し、一度も使用していない |
| 配送料の負担: | 送料込み(出品者負担) |
| 配送の方法: | 佐川急便/日本郵便 |
| 発送元の地域: | 東京都 |
| 発送までの日数: | 1~2日で発送 |
レビュー
商品の評価:




 4.8点(4008件)
4.8点(4008件)
- DAISHI♂
- 特に問題無く使用出来、価格もリーズナブルでよかったです。
- スーパーマン3032
- 確かにテレビ等に転送はできます。ただそれだけです。画質その他気にしないならまあいいかな。そんな感じです。ただし注意。日本語説明書付属のような記述がありますが、英語のみで、日本語説明書など付属しません。アプリのリンクが画面に表示されますが、アップルストアにも日本語表示ありませんので怖くて使えませんのでこれ以上の論評はできません
- えどまえ。
- INS電話、FAXを使うために購入。今更なので、高いTAを買う気はなく中古を探して購入。問題なしで稼働中。
- umestar6693
- ターミナルアダプタが故障したので交換用に購入しましたが、値段が格安なので良かったと思います。問題なく使用できています。
- ably6051
- レグザZ8のタイムシフトプラス1用に購入しました。 問題なく利用できています。
- 1マックス
- 現在使用しているものが故障したので慌てて購入しました。 まだネットにはつなげていませんが、FAXの接続など簡単に行え現在問題なく使用できています。
- aki1170207
- 業務用に2つ購入しましたが、1つ初期不良でした。 メーカー保証がついているので、問題ないですが 評価を3つに
- まぁゆん0527
- 事務所が ISDNを使用していて 古いルータの設定が困難の為 購入しました。 CDROMが VISTAまでしか対応していないので WIN7では USBドライバーが インストール出来ません。 NTTサイトに 新しいドライバーがないか 探しましたが ISDNは これで止まってしまっていますね。 電話機からの設定を 説明書を見ながら 淡々と行い 何とか取付は完了しました。
- えびちり1
- まだ商品は来てませんが、楽しみにしています。
- ラパージュ
- ショップからの連絡がおそく催促するまで、メールの返信が無い。催促後は、すぐに届きました。商品は大丈夫でした。のんびり待てる人は良いと思います。
- 夢一番!
- 充電に時間かかりますが 十分つかえます スマホなどは電池消費するので1個は少し心配
- hakka6811
- 去年、新しく買ったPCにモデムが内蔵されていなかったので購入。 必要なときだけUSB接続で手軽に使えるので便利。 従来の「ピーッ ガガガ…」という接続したときの音が無いのがちょっと寂しい(笑)
- ikunnotomo
- 本当はシリアル接続の方が良いのだろうが、最近のPCにはシリアルポートが無くUSBシリアル変換ケーブルを使うくらいならと買ってみた。一昔前のモデムのように通信の主役ではなくなり見てくれもチープでインジケーターもスピカーも無いが、FAXを送ることは出来るのでよしとする。ただ、相手FAXとの接続を音で確かめる癖が抜けないので違和感はある。
すべて見る
お店の情報
7,367
連絡・応対
4.3
配送スピード
4.3
梱包
4.3










![たにひろ様 THP 1ml Detailed Information [JCRB0112.1]-](/pbagn/nHE0pHZ6Yy9zdGS0nWMubWIyY2RuLz5ldC9cdGItL2EldGFcbP9vpmlnL3Oob3/Evcy9tMzx5NmVzNzgzMTZfZS5qcGc-.jpg)
![Detailed Information [JCRB0112.1]-](/pbagn/nHE0pHZ6Yy9jZWksLmFuay5uaWJuLzdvLmcjL35jZWksYmFhal9poWFnZXZvcG/yjdHVyZXMvSkASQjAxMTIxK1RIUDSfMDcxNjIwZjVfMDA2YkpQRw--.jpg)


![Detailed Information [JCRB0112.1]-](/pbagn/nHE0pHZ6Yy9jZWksLmFuay5uaWJuLzdvLmcjL35jZWksYmFhal9poWFnZXZvcG/yjdHVyZXMvSkASQjAxMTIxK1RIUDSfMDkwMzIwZTBfMDA0YkpQRw--.jpg)

































